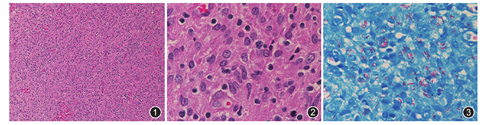

版权归中华医学会所有。
未经授权,不得转载、摘编本刊文章,不得使用本刊的版式设计。
除非特别声明,本刊刊出的所有文章不代表中华医学会和本刊编委会的观点。
患者男,21岁。2016年8月10日自觉左颈部肿胀伴疼痛,次日开始发烧,最高体温40 ℃,抗炎治疗无效,8月26日就诊当地医院,正电子发射计算机断层显像(PET-CT)检测显示咽旁、颌下区、胸锁乳突肌区、颈根部及锁骨上窝多发淋巴结肿大,SUVmax 12.8;脾大、心包积液。激素治疗后体温下降,淋巴结也有缩小,但是停药后体温再次升高,淋巴结也增大。9月12日切除右颈部淋巴结活检。骨髓活检:中性分叶核粒细胞比例增高,余未见异常,血常规提示白细胞升高,中性粒细胞比例增高。
(1)大体观察:淋巴结一枚,体积1.3 cm×1.0 cm×0.8 cm,表面光滑,切面灰白、粉红质中。(2)镜下观察:淋巴结被膜不厚,正常结构消失,未见明显滤泡结构,间质小血管增生,可见弥漫成片的粉染区,以组织细胞为主,局部呈旋涡状改变,背景细胞成分杂,有小淋巴细胞、浆细胞、树状突细胞、中性粒细胞及少许免疫母细胞浸润,呈炎性改变。淋巴细胞未见明显异型,局部可见少量的核碎片(图1,图2)。结合患者病史及形态学改变,不同单位的病理医师在讨论中考虑的诊断主要集中于以下几种疾病:Kikuchi病、炎性假瘤、霍奇金淋巴瘤(HL)、富于淋巴组织细胞的间变性大细胞淋巴瘤(ALCL)、非特殊型外周T细胞淋巴瘤(PTCL-NOS)、血管免疫母细胞T细胞淋巴瘤(AILT)。


(1)免疫组织化学染色结果:CD21染色未见FDC网的存在,提示淋巴结固有结构消失,这点需要与淋巴瘤鉴别,因为很多淋巴瘤都可能破坏淋巴结固有结构,伴有炎性背景。但是,CD20显示少量淋巴细胞阳性,CD3显示较多T细胞阳性,不成片,且细胞体积不大,数量明显多于CD20阳性的B细胞,Ki-67阳性指数约10%~20%,以上免疫组织化学结果支持为炎性病变。仔细观察病变内T细胞无明显异型性,免疫组织化学CD3阳性的T细胞体积不大,且散在、不成片,不支持典型T细胞淋巴瘤的诊断;病变内可见散在CD30阳性细胞,但强弱不等,提示为活化的免疫母细胞,同时加做CD15和PAX5染色,均未见阳性表达的大细胞,可以排除霍奇金淋巴瘤。本例为年轻人,起病急,高热,加做间变性淋巴瘤激酶(ALK)、上皮细胞膜抗原(EMA)均阴性,排除了间变性大细胞淋巴瘤的可能。(2)齐尔-尼尔森(Ziehl-Neelsen)抗酸染色:可见阳性抗酸杆菌(图3)。(3)分子检测:结核杆菌核酸检测(PCR-荧光法)提示阳性。证实为结核杆菌感染。同时行EBER原位杂交检测未见阳性,提示没有EB病毒的感染。
(右颈部)淋巴结组织细胞为主的炎性病变中查见大量抗酸杆菌,结核杆菌核酸检测阳性,符合结核性淋巴结炎。
本例患者病情严重,发烧未能控制住,口腔里大量毛白斑,镜下见大量的霉菌及孢子,多次检测人免疫缺陷病毒(HIV)、梅毒和EB病毒均阴性,于会诊后一周去世。
本例为年轻人,病程短,系统性症状,多发淋巴结肿大,脾大,心包积液,伴发热。组织形态学表现为大量组织细胞聚集,背景细胞成分杂,需要与伴有大量炎性背景的淋巴瘤鉴别。本例病变内细胞未见明显异型,T细胞不呈片,Ki-67阳性指数不高,抗酸染色及结核杆菌核酸检测阳性,符合结核性淋巴结炎改变。本例的特殊之处在于未见明显的肉芽肿结构及干酪样坏死,主要为组织细胞。而且本例患者临床表现为高热,最高体温40 ℃,PET-CT提示全身多发淋巴结肿大,SUVmax 12.8,很难想到结核杆菌的感染。典型结核一般累及外周淋巴结,以颈部淋巴结受累最多见,淋巴结肿大可以是其首发症状[1]。PET-CT检查SUV值一般不高,仅见个案报道可以出现淋巴瘤样的高SUV值表现[2]。结核性淋巴结炎在组织学上常表现为明显肉芽肿结节,典型的结核肉芽肿为干酪样坏死、环绕坏死周围的朗格汉斯细胞、上皮样细胞和淋巴细胞,朗格汉斯细胞是上皮样细胞融合而成,具有强嗜碱性胞质,多个核沿细胞周边排列,痊愈病变可出现纤维化及钙化[3]。抗酸染色可以显示分枝杆菌,通过PCR可以识别分枝杆菌的菌种。本例组织切片中,没有看到明显的肉芽肿结构,也没有出现提示性的朗格汉斯细胞及干酪样坏死,只是有少量的核碎片及中性粒细胞;在免疫缺陷的患者中,肉芽肿结节未充分形成时可以伴有较多的中性粒细胞。我们通过抗酸染色找到了大量的抗酸杆菌,结核杆菌核酸检测阳性,也证实为结核杆菌。本例提出讨论的价值在于,当结核性淋巴结炎没有特异性的症状,镜下形态又不典型时,我们如果没有做抗酸染色,只能考虑炎性病变,无法做出明确的诊断,而且很容易漏诊。而结核和普通炎性病变的治疗是完全不同的,本例病情未得到控制而出现广泛播散,不是因为患者存在免疫缺陷(多次检查HIV均阴性),而是因为没有得到明确诊断和及时的抗结核治疗,又因高热而采用激素治疗,很可能造成了结核的播散,加重患者的病情并出现严重后果。因此,加强对不典型结核病的警惕,加强结核菌的检测,及时准确诊断出结核病,非常重要[4]。
(1)Kikuchi病(组织细胞坏死性淋巴结炎):多发生于青年女性,最常累及颈部淋巴结,淋巴结肿大与发热相关,多数高热(高及39 ℃以上),白细胞降低,抗生素治疗无效,自限性疾病,多数2~4周痊愈。镜下诊断的依据为:淋巴结斑片状部分受累、富含核碎屑、含有新月形组织细胞的混合性细胞浸润。很多以碎屑状坏死为主的淋巴结结核病会误诊Kikuchi病,本例临床症状相似,但是实验室检查白细胞升高,而且镜下形态虽然富于组织细胞,但核碎不明显,低倍镜下不是斑片状受累,而且病灶内有中性粒细胞,患者病情呈持续性进展、无自发好转倾向,均不支持Kikuchi病[5,6]。(2)炎性假瘤:是一种多发于年轻成人(中位年龄33岁)的淋巴结特发性疾病,患者有全身症状和实验室检查异常,如高γ球蛋白血症、血沉上升和贫血[7]。可累及单个淋巴结或多组外周淋巴结、纵隔淋巴结和脾。本病最为关键的组织学特征为淋巴结结缔组织网的纤维炎性反应,并且可以蔓延至淋巴结周围的软组织中。病灶中有增生的小血管、组织细胞、肌纤维母细胞,混合有淋巴细胞、浆细胞、嗜酸性粒细胞和中性粒细胞。病变中通常无滤泡结构。免疫组织化学染色显示淋巴细胞主要为T细胞,组织细胞表达CD68,梭形细胞表达波形蛋白和actin,这组免疫表型提示炎性假瘤是一类纤维组织细胞增生性病变,本例的形态和免疫表型很像炎性假瘤,但是纤维母细胞不明显,抗酸染色及结核杆菌核酸检测阳性,可以排除。(3)T细胞淋巴瘤:外周T细胞淋巴瘤或血管免疫母细胞T细胞淋巴瘤,均可以出现全身系统性症状、高SUV值和组织学上的炎性背景,是本例最需要鉴别的疾病。本病例CD21未见FDC网的存在,提示淋巴结正常结构消失,CD3阳性的T细胞多于CD20阳性的B细胞,但是细胞散在,不成片或弥漫,体积不大,无明显异型性,均不支持T细胞淋巴瘤。(4)霍奇金淋巴瘤:青壮年期是霍奇金淋巴瘤的发病高峰,本例为年轻患者,出现全身系统性症状,临床及影像学均提示肿瘤性改变,病理形态学表现为炎性背景,虽然未见典型的霍奇金样细胞,但也是需要鉴别诊断。本例通过免疫组织化学染色未见CD15、CD30和PAX5阳性的肿瘤细胞,可以除外霍奇金淋巴瘤。(5)间变性大细胞淋巴瘤:本例为年轻人,高热、急性起病,淋巴结病变内大量组织细胞,我们很容易想到间变性大细胞淋巴瘤(淋巴组织细胞亚型),但是形态学没有找到间变性大细胞淋巴瘤的标志性瘤细胞(Hallmark cell),且免疫组织化学上皮细胞膜抗原及ALK阴性,可以排除。
本文讨论了1例具有特殊形态学的结核性淋巴结炎,没有典型的肉芽肿结构,病变内可见丰富的组织细胞,如果不做抗酸染色,很容易漏诊分枝杆菌的感染;结核杆菌的PCR检测进一步证实为结核杆菌引起的病变。本例给我们的提示:(1)临床出现发热及全身淋巴结肿大,淋巴结病变中见到大量组织细胞,炎性背景中的淋巴细胞缺乏明显异型时,在排除淋巴瘤的诊断后,我们还要想到分枝杆菌感染的可能,并加做抗酸染色;(2)如果开展了基因检测,我们可以通过结核杆菌核酸的PCR进一步证实是否为结核杆菌感染。